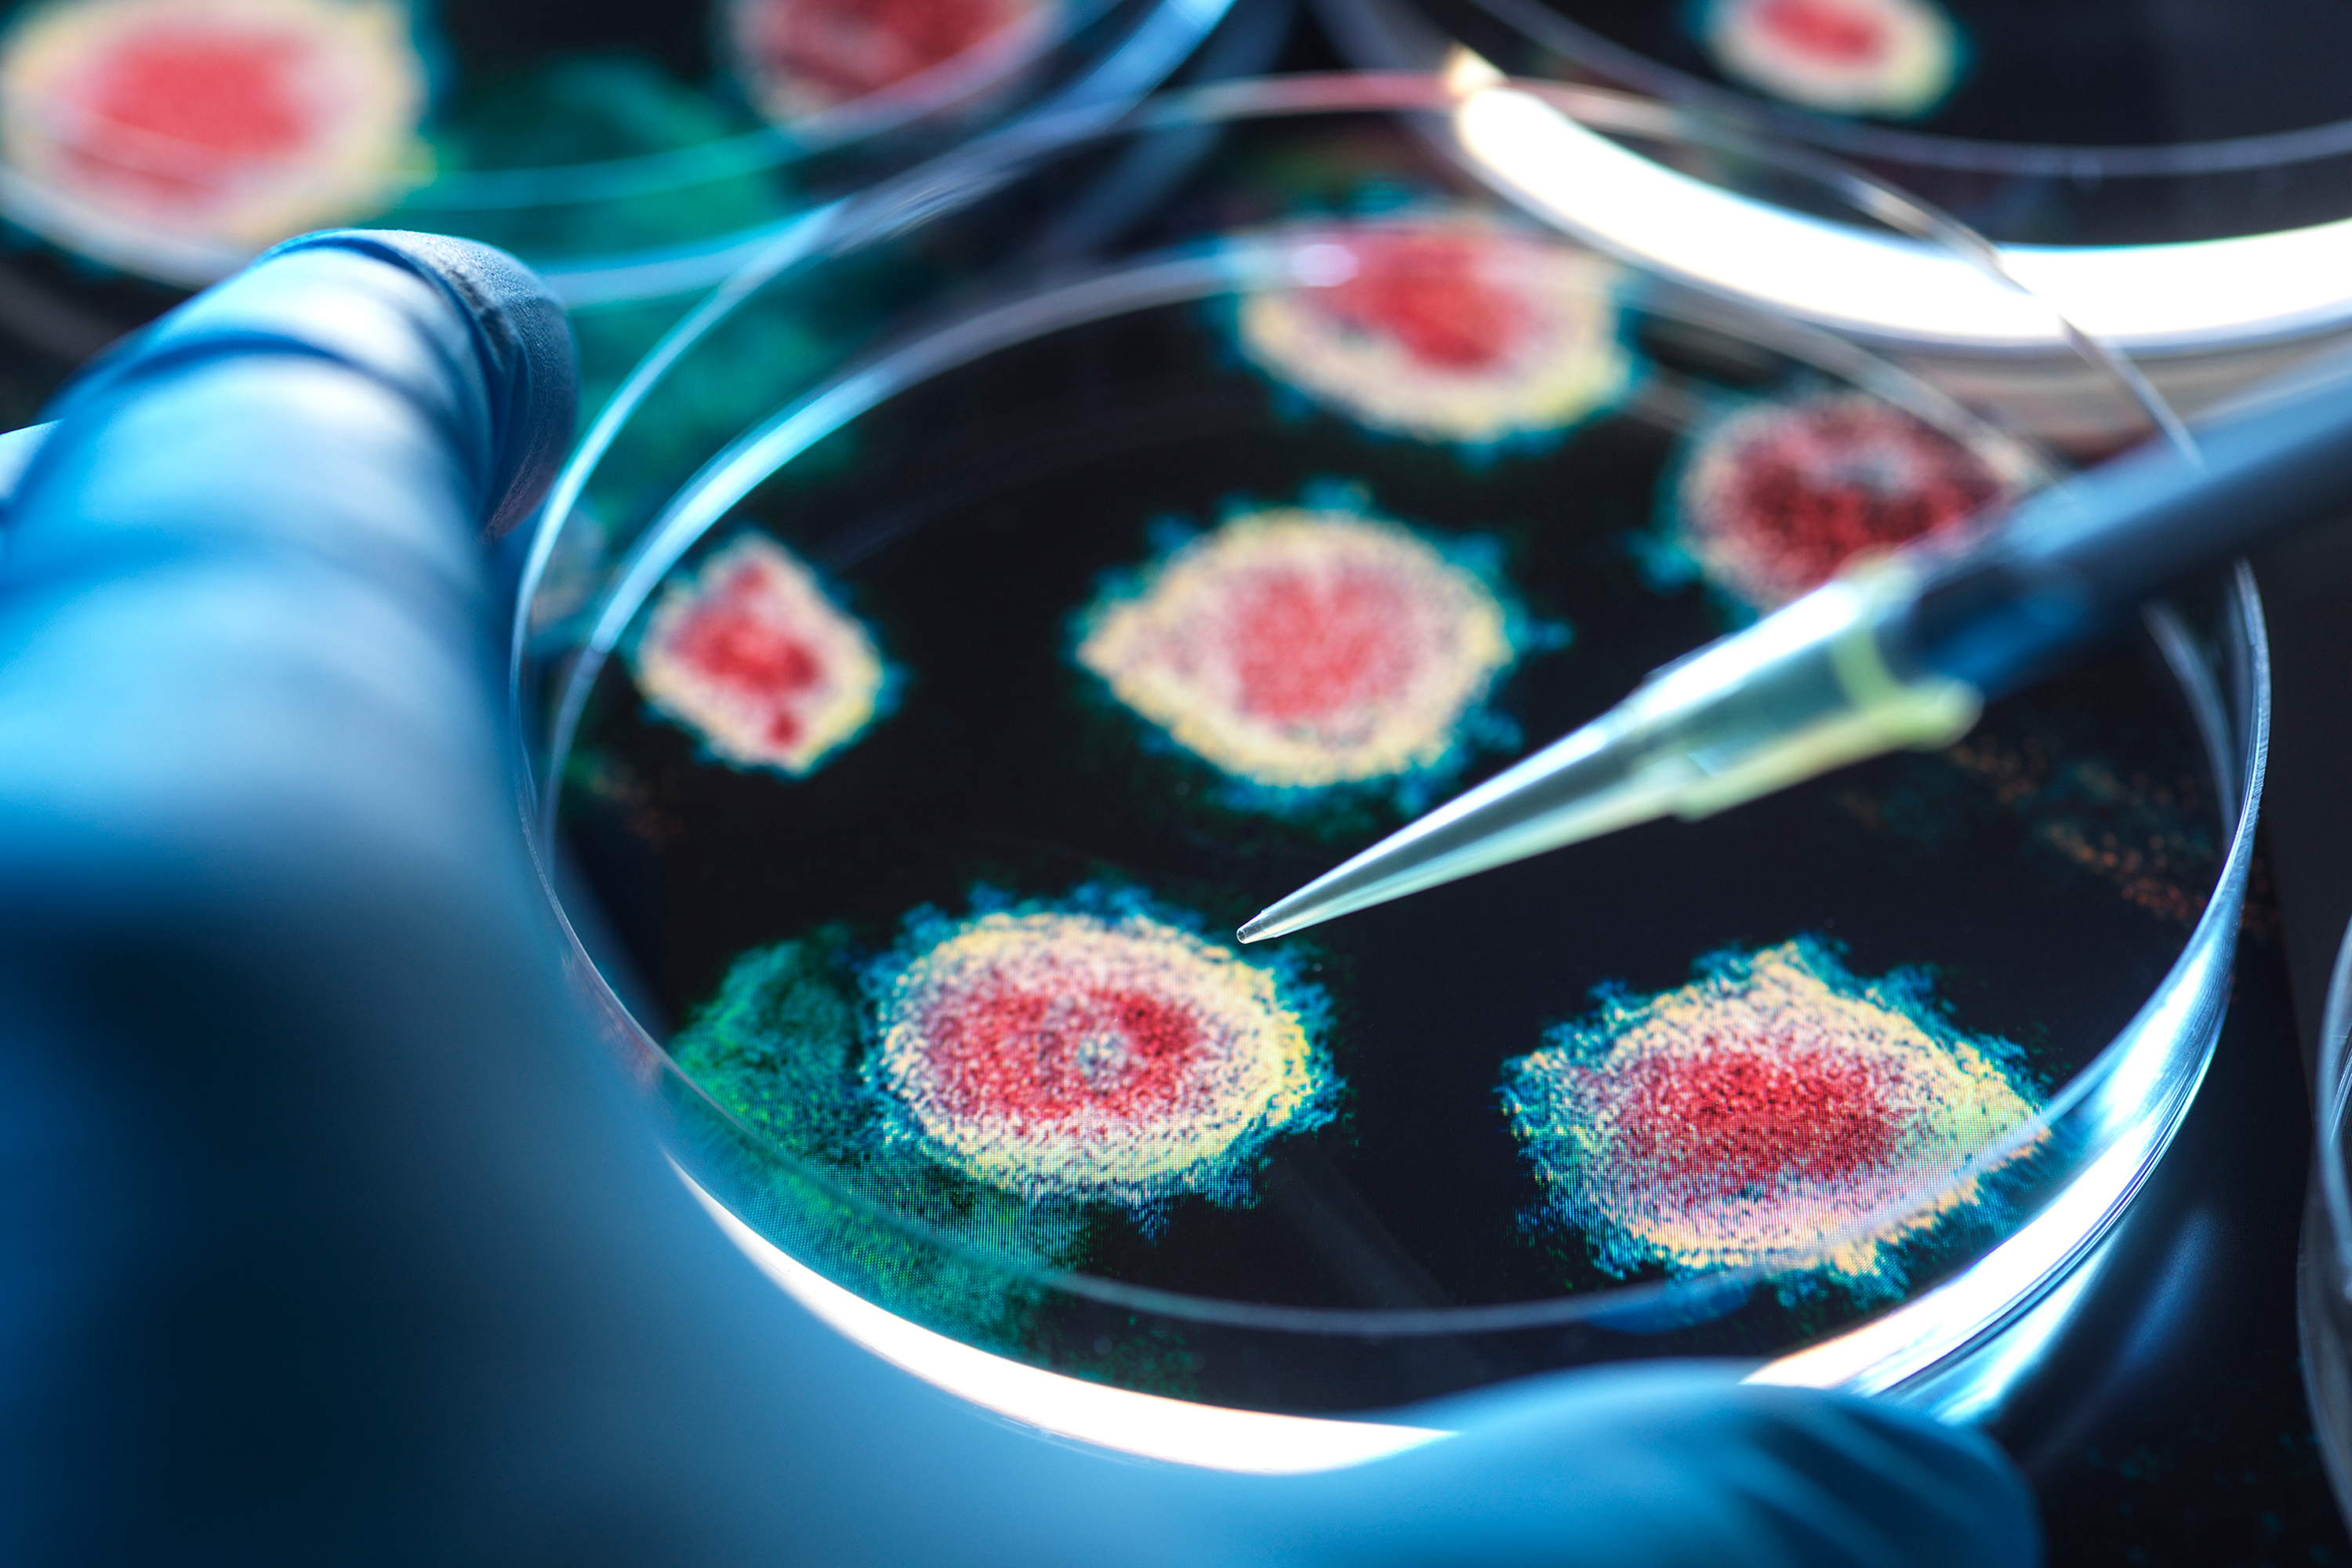
Újabb riogatás a Covid-variáns, amire nem hatnak a vakcinák? 2 Vírusok

Sorra jönnek a koronavírus ilyen-olyan variánsai, az emberek már tényleg jogosan érzik azt, hogy riogatják őket. Mert azt már csak ritkán teszik hozzá, mi mit jelent és az információkat hogyan kell kezelni
– mondja Dr. Kemenesi Gábor a 24.hu-nak, amikor az „alattomban terjedő”, új koronavírus-variánsról kérdezzük. A Covid-pandémia a világ minden társadalmát megrázta, mély nyomokat hagyott, így nem csoda, ha a nemzetközi sajtó fokozott figyelemmel kíséri a kórokozó körüli történéseket. Laikusként viszont elég rosszul hangzik, amit erről a változatról – nevezzük nevén: BA. 3.2 – hallunk, olvasunk: nagy mértékben mutálódott, 70-75 változást szedett össze a tüskefehérjéjén. Emiatt félő, hogy kikerüli a forgalomban lévő vakcinák védelmét, az Egészségügyi Világszervezet (WHO) felvette a megfigyelendő variánsok listájára. Először Dél-Afrikában írták le 2024 őszén, azóta szinte észrevétlenül terjedt, ezért kapta a cicada, azaz a rejtőzködő életmódot folytató kabóca becenevet. Mára a világ több tucat országában jelen van, néhol már a fertőzések 30 százalékáért felelős. Sokan attól tartanak, hogy hamarosan dominánssá válik, és ez valóban lehet aggasztó egy potenciálisan vakcinakerülő vírussal kapcsolatban. Mi az igazság? Erről kérdeztük a virológust, a Pécsi Tudományegyetem Virológiai Nemzeti Laboratórium vezetőjét.
A lényeg, hogy miben változott
Érdemes általánosságban kezdeni. Bármilyen kórokozóval, de főleg vírusokkal kapcsolatban azt kell megérteni, hogy folyamatosan változnak, mondjuk úgy, csiszolják magukat, ez a folyamat vezet törvényszerűen újabb és újabb változatok kialakulásához. Így működik a természet, az evolúció. Aztán a média időről időre felkapja valamelyiket mondjuk azért, mert jaj, mennyi mutáció van benne, most aztán „valóban mind meghalunk”. Csakhogy:
Önmagában az, hány mutációt szedett fel, még nem sokat jelent. A hol kérdése már adhat egy kis felkiáltójelet, de a lényeg az, hogy adott változások funkcionálisan mit jelentenek
– fogalmaz Kemenesi Gábor, és példákkal folytatja.
Tegyük fel, jobban kötődik a receptorokhoz, és kikerüli a meglévő, antitest alapú készítményeket – az antitest-terápia bevett gyógymód, hatékonyan leköti a vírusokat a szervezetben. Ilyenkor igen, egy kezelési mód átmenetileg kiesik, amíg nem fejlesztenek helyette új, hatékonyabb hatóanyagot. Vagy nézzük a vakcinákat. Szervezetünk a közreműködésükkel kezd antitestek „gyártásába”, sokat és sokfélét állít elő, ezek közül pedig többen is hatásosak lesznek adott variáns ellen, így jó védelmet biztosítanak.
Ha jön egy új vírus, amiben nagyon sok a mutáció, és mondjuk pont a védelmi rendszerünk által célzott pontokat alakította át, akkor a vakcina kicsit kevésbé lesz hatásos.
Ám még ekkor is alapszabály, hogy a komplexebb oltóanyagok a súlyos betegségtől nagyon nagy valószínűséggel megvédenek.
A kutatók nekiugranak
Nézzük most konkrétan a BA.3.2-t. A kabóca nevet a média ragasztotta rá, ennek nincs jelentősége. Mint említettük, 2024-ben fedezték fel Dél-Afrikában, mindeddig a háttérben maradt, mostanában tűnik úgy, mintha, talán kezdene dominánssá válni. Egy-egy variáns előretörésének rendkívül összetett okai vannak, egyelőre nem tudjuk, miért éppen ez kezdett el „erősödni”. Mint minden hasonló esetben, a BA.3.2 is felkerült a WHO monitorozandó vírusok listájára, ami nem valami rangsor, statisztika vagy riogatás, hanem jelzés a tudományos világ felé.
Ilyenkor a kutatók nekiugranak, megvizsgálják az új variáns összes egészségügyi, járványügyi szempontból fontos paraméterét. Itt tartunk most. Amennyiben kiderül, hogy hatékonyan kikerüli például a vakcina adta antitest-immunitást, akkor már megy is tovább az üzenet: az oltóanyag-komponenst ehhez kell majd igazítani.
Aggodalomra tehát semmi ok, ezek a mechanizmusok már rutinszerűen működnek a Covid esetében is. Mint az influenzánál: ha új változat válik dominánssá, akkor adott szezonban már hozzá igazítják az oltóanyagot
– emeli ki a virológus. Hozzáteszi: a BA.3.2 valóban sok mutációt szedett össze, mondjuk úgy, az átlagnál többet, ám nem kiemelkedő, láttunk már pár hasonlót az elmúlt években.
Nincs látnivaló
Az új változatok esetében a laikus egyik legelső kérdése: milyen tüneteket okoz. Újdonság itt sincs, elsősorban légúti fertőzésről beszélünk ide kapcsolódó tünetekkel: orrfolyás, orrdugulás, fejfájás, fáradtság, levertség, köhögés, tüsszögés. Illetve bizonyos betegeknél hasmenéses megbetegedést is okozhat. Emellett sokan számoltak be torokfájásról, ami más variánsoknál nem ennyire domináns, viszont arra sem alkalmas, hogy e tünet alapján öndiagnózist végezzünk.
Ugyancsak változatlan alapigazság a védekezés módja: Covid-időszakban maszk viselése ajánlott, fertőtlenítés, kézmosás, és aki beteg, az maradjon otthon, ne fertőzzön meg másokat. Emellett el kell fogadni, hogy a társadalom egy részét bizony súlyosan érintheti ez a vírus, számukra rendkívül fontos a vakcina felvétele.
Végszóként a virológus kiemeli: „A járvány kitörése után ennyi évvel magabiztosan el lehet mondani: nincs különös látnivaló, de az újabb mutációk megjelenését, a védekezés módszereit és a vakcina fontosságát végre meg kell érteni és el kell fogadni. Ha ez megvan, akkor a következő »mind meghalunk” típusú riogatás is hidegen hagy majd”.
További témáink kórokozók világáról:
Csak védőruhában engedték terepre a magyar kutatókat a fertőzött kullancsok miatt
Kevesebb vakcina, több vörös hús – veszélyes irányt vett az amerikai egészségügy RFK Jr. alatt
Virológust kérdeztünk: az egyik leghalálosabb vírus Magyarországon is feltűnhet?
Ezreket fertőzhetett meg hazánkban a nyugat-nílusi vírus
The post Újabb riogatás a Covid-variáns, amire nem hatnak a vakcinák? first appeared on 24.hu.
Tovább az erdeti cikkre:: 24.hu





